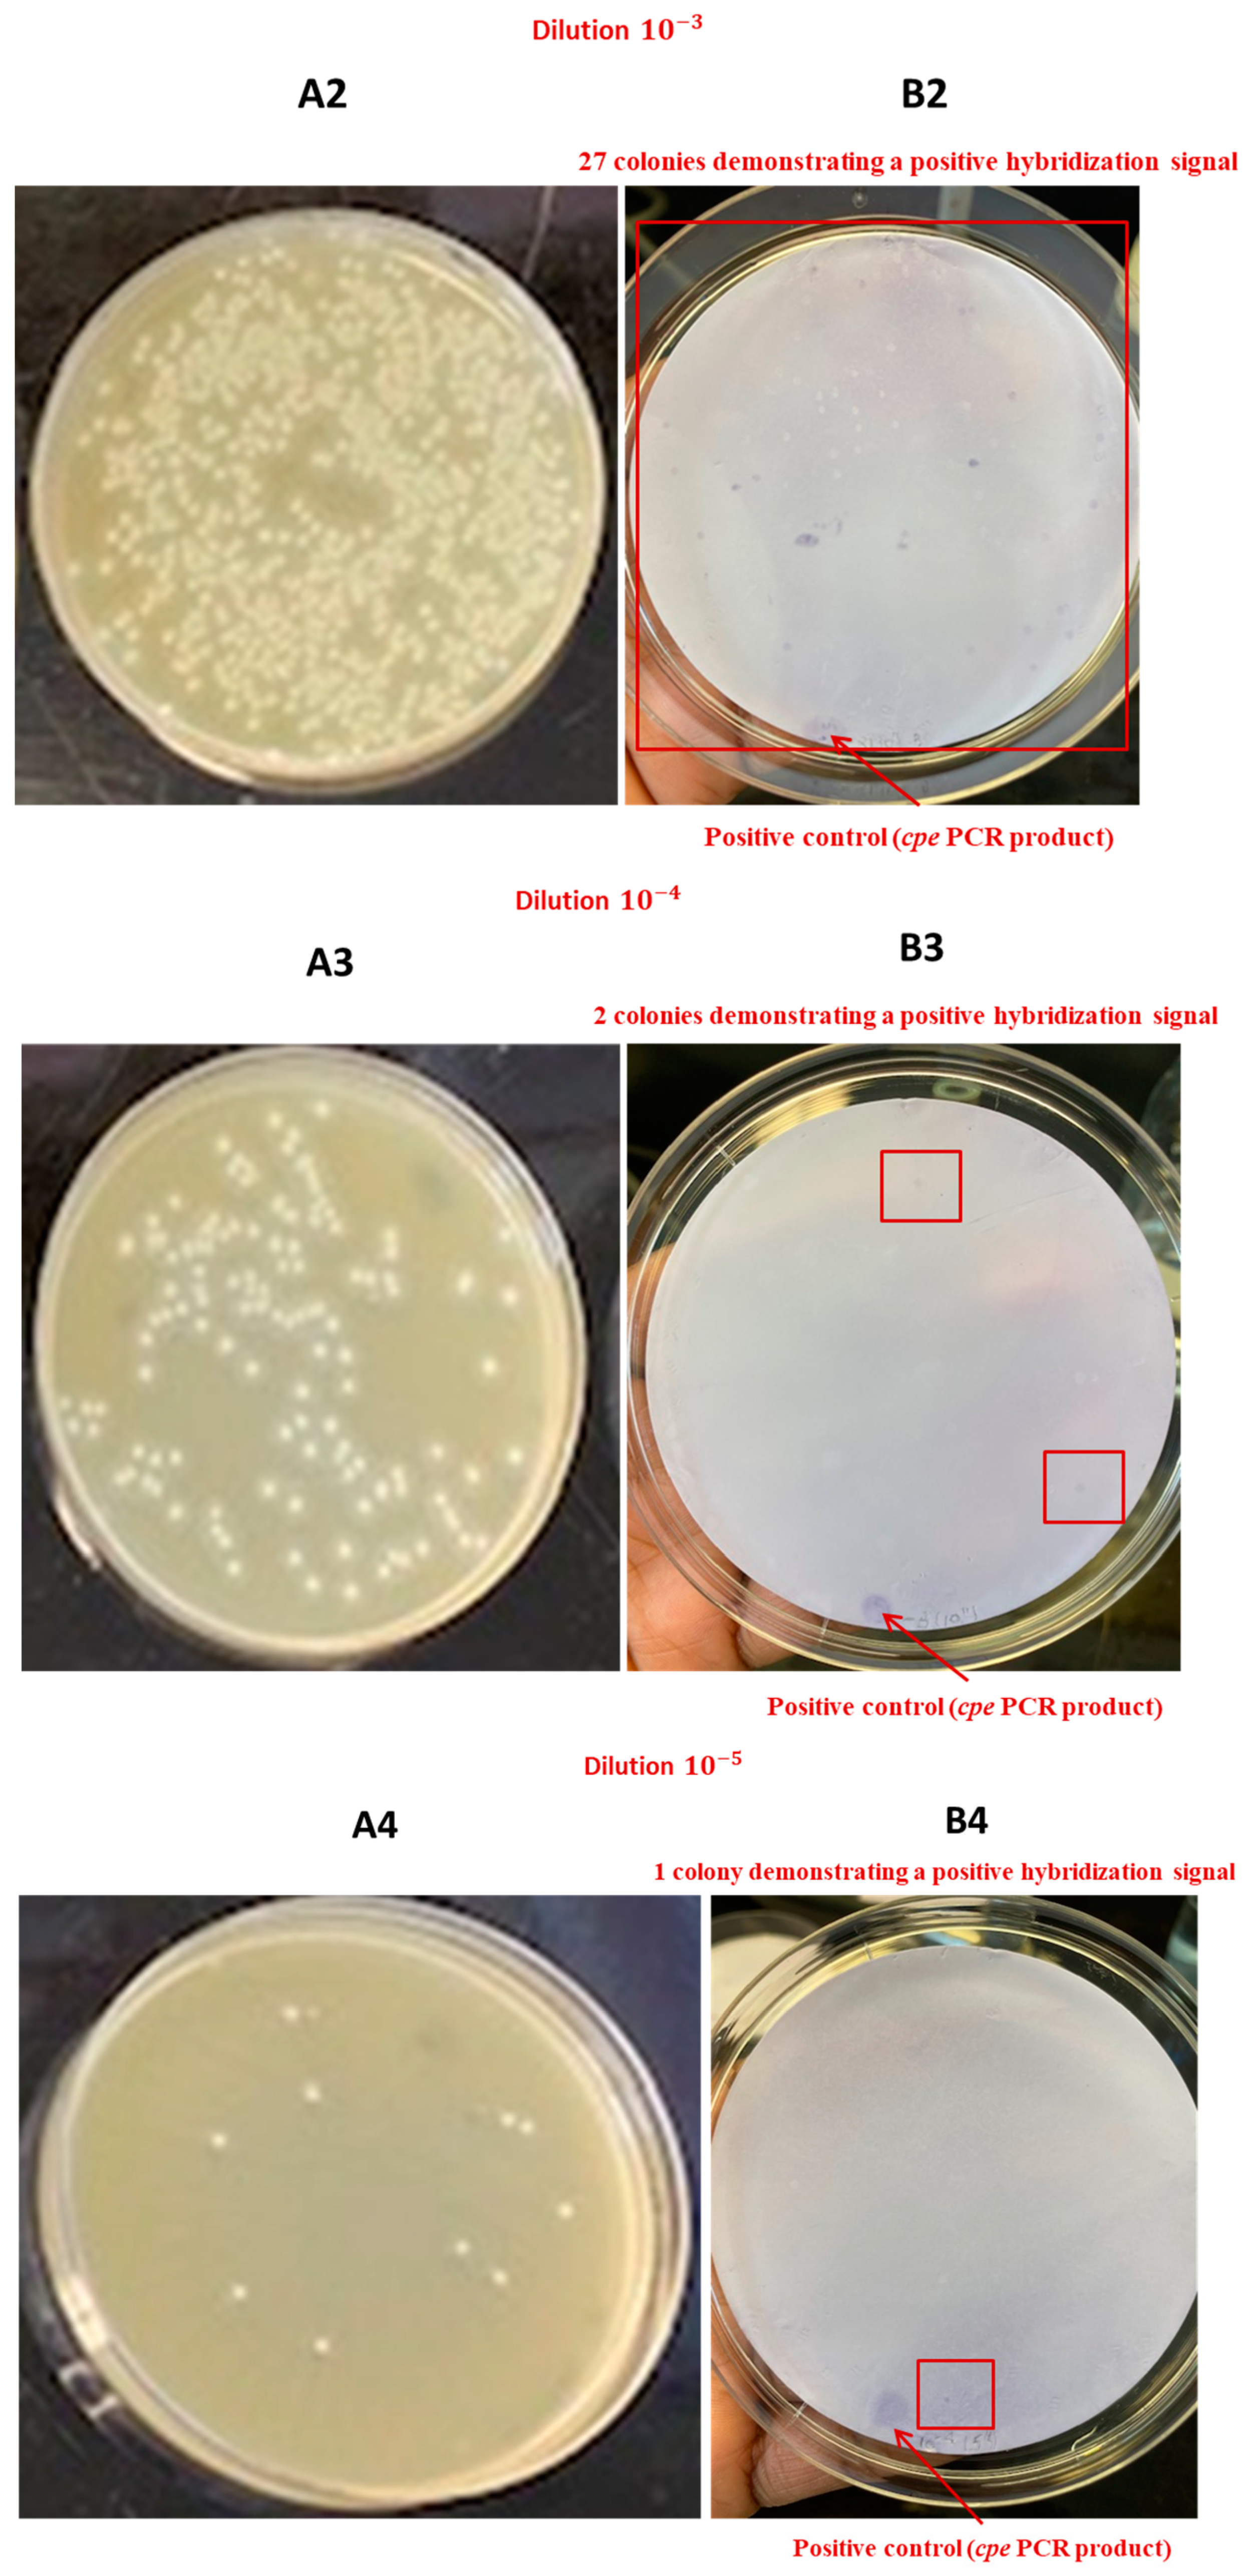
Pathogens 13 00030 g012b Pathogens 13 00030 g012b

Addressing Current Challenges in Poultry Meat Safety: Development of a Cultivation and Colony Hybridization Approach to Recover Enterotoxigenic Clostridium perfringens from Broiler Chicken Carcasses
Abstract
1. Introduction
2. Materials and Methods
2.1. Sampling
2.2. DNA Extraction
2.3. Synthesis of the Digoxigenin-Labeled DNA Probe Targeting cpe
2.4. Hybridization of the Labeled Probe on Bacterial Genomic DNA and Pure Lysed Colonies of Enterotoxigenic C. perfringens AHL 311 Control Strain and C. perfringens ATCC 13124 Reference Strain
2.5. Detection of the cpe Gene from Sterile Freezing Medium Artificially Contaminated with C. perfringens AHL 311 Control Strain Using Hydrophobic Membrane Grid Filtration and Colony Hybridization
2.6. Detection of the cpe Gene in Broiler Chicken Carcass Rinsates Artificially Contaminated with C. perfringens AHL 311 Control Strain Using Hydrophobic Membrane Grid Filtration and Colony Hybridization (HGMF-CH)
2.7. Detection of the cpe Gene in Broiler Chicken Carcass Rinsates Artificially Contaminated with C. perfringens AHL 311 Control Strain Using a Combination of Direct Plating and Colony Hybridization (DP-CH)
3. Results
3.1. Sampling
3.2. DNA Extraction
3.3. Synthesis of the Digoxigenin-Labeled DNA Probe Targeting cpe
3.4. Hybridization of the Labeled Probe and the cpe Gene from Bacterial Genomic DNA or Pure Lysed Bacterial Cells from C. perfringens AHL 311 Control Strain and C. perfringens Reference Strain ATCC 13124
3.5. Detection of the cpe Gene from Sterile Freezing Medium Artificially Contaminated with C. perfringens AHL 311 Using a Hydrophobic Grid Membrane Filtration and Colony Hybridization (HGMF-CH) Approach
3.6. Detection of the cpe Gene from Broiler Chicken Carcass Rinsates Artificially Contaminated with C. perfringens AHL 311 Control Strain Using Hydrophobic Grid Membrane Filtration and Colony Hybridization
3.7. Detection of the cpe Gene from Broiler Chicken Carcass Rinsates Artificially Contaminated with C. perfringens AHL 311 Using a Combination of Direct Plating and Colony Hybridization (DP-CH)
4. Discussion
5. Conclusions
Author Contributions
Funding
Institutional Review Board Statement
Informed Consent Statement
Data Availability Statement
Acknowledgments
Conflicts of Interest
References
- Kiu, R.; Hall, L.J. An update on the human and animal enteric pathogen Clostridium perfringens. Emerg. Microbes Infect. 2018, 7, 141. [Google Scholar] [CrossRef]
- McClane, B.A.; Robertson, S.L.; Li, J. Clostridium perfringens. In Food Microbiology: Fundamentals and Frontiers, 4th ed.; Michael, R.L.B., Doyle, P., Eds.; Wiley: Hoboken, NJ, USA, 2012; pp. 465–489. [Google Scholar]
- Uzal, F.A.; Freedman, J.C.; Shrestha, A.; Theoret, J.R.; Garcia, J.; Awad, M.M.; Adams, V.; Moore, R.J.; Rood, J.I.; McClane, B.A.; et al. Towards an understanding of the role of Clostridium perfringens toxins in human and animal disease. Futur. Microbiol. 2014, 9, 361–377. [Google Scholar] [CrossRef]
- Rood, J.I.; Adams, V.; Lacey, J.; Lyras, D.; McClane, B.A.; Melville, S.B.; Moore, R.J.; Popoff, M.R.; Sarker, M.R.; Songer, J.G.; et al. Expansion of the Clostridium perfringens toxin-based typing scheme. Anaerobe 2018, 53, 5–10. [Google Scholar] [CrossRef] [PubMed]
- Heredia, N.L.; Labbé, R.G. Clostridium perfringens. In Guide to Foodborne Pathogens; Wiley: Hoboken, NJ, USA, 2013; pp. 133–142. [Google Scholar]
- Lindström, M.; Heikinheimo, A.; Lahti, P.; Korkeala, H. Novel insights into the epidemiology of Clostridium perfringens type A food poisoning. Food Microbiol. 2011, 28, 192–198. [Google Scholar] [CrossRef] [PubMed]
- Grass, J.E.; Gould, L.H.; Mahon, B.E. Epidemiology of foodborne disease outbreaks caused by Clostridium perfringens, United States, 1998–2010. Foodborne Pathog. Dis. 2013, 10, 131–136. [Google Scholar] [CrossRef] [PubMed]
- Tam, C.C.; Rodrigues, L.C.; Viviani, L.; Dodds, J.P.; Evans, M.R.; Hunter, P.R.; Gray, J.J.; Letley, L.H.; Rait, G.; Tompkins, D.S.; et al. Longitudinal study of infectious intestinal disease in the UK (IID2 study): Incidence in the community and presenting to general practice. Gut 2011, 61, 69–77. [Google Scholar] [CrossRef] [PubMed]
- Butler, A.J.; Thomas, M.K.; Pintar, K.D. Expert Elicitation as a Means to Attribute 28 Enteric Pathogens to Foodborne, Waterborne, Animal Contact, and Person-to-Person Transmission Routes in Canada. Foodborne Pathog. Dis. 2015, 12, 335–344. [Google Scholar] [CrossRef] [PubMed]
- Havelaar, A.H.; Galindo, V.; Kurowicka, D.; Cooke, R.M. Attribution of Foodborne Pathogens Using Structured Expert Elicitation. Foodborne Pathog. Dis. 2008, 5, 649–659. [Google Scholar] [CrossRef]
- McClung, L.S. Human food poisoning due to growth of Clostridium perfringens (C. welchii) in freshly cooked chicken. J. Bacteriol. 1945, 50, 229–231. [Google Scholar] [CrossRef]
- Miki, Y.; Miyamoto, K.; Kaneko-Hirano, I.; Fujiuchi, K.; Akimoto, S. Prevalence and Characterization of Enterotoxin Gene-Carrying Clostridium perfringens Isolates from Retail Meat Products in Japan. Appl. Environ. Microbiol. 2008, 74, 5366–5372. [Google Scholar] [CrossRef]
- Guran, H.S.; Oksuztepe, G. Detection and typing of Clostridium perfringens from retail chicken meat parts. Lett. Appl. Microbiol. 2013, 57, 77–82. [Google Scholar] [CrossRef] [PubMed]
- Lin, Y.-T.; Labbe, R. Enterotoxigenicity and Genetic Relatedness of Clostridium perfringens Isolates from Retail Foods in the United States. Appl. Environ. Microbiol. 2003, 69, 1642–1646. [Google Scholar] [CrossRef] [PubMed]
- Nowell, V.J.; Poppe, C.; Parreira, V.R.; Jiang, Y.-F.; Reid-Smith, R.; Prescott, J.F. Clostridium perfringens in retail chicken. Anaerobe 2009, 16, 314–315. [Google Scholar] [CrossRef] [PubMed]
- Miwa, N.; Nishina, T.; Kubo, S.; Atsumi, M.; Honda, H. Amount of enterotoxigenic Clostridium perfringens in meat detected by nested PCR. Int. J. Food Microbiol. 1998, 42, 195–200. [Google Scholar] [CrossRef]
- Wen, Q.; McClane, B.A. Detection of Enterotoxigenic Clostridium perfringens Type A Isolates in American Retail Foods. Appl. Environ. Microbiol. 2004, 70, 2685–2691. [Google Scholar] [CrossRef]
- Hu, W.-S.; Kim, H.; Koo, O.K. Molecular genotyping, biofilm formation and antibiotic resistance of enterotoxigenic Clostridium perfringens isolated from meat supplied to school cafeterias in South Korea. Anaerobe 2018, 52, 115–121. [Google Scholar] [CrossRef]
- Gaucher, M.-L.; Thibodeau, A.; Fravalo, P.; Archambault, M.; Arsenault, J.; Fournaise, S.; Letellier, A.; Quessy, S. Broiler chicken carcasses and their associated abattoirs as a source of enterotoxigenic Clostridium perfringens: Prevalence and critical steps for contamination. AIMS Microbiol. 2018, 4, 439–454. [Google Scholar] [CrossRef]
- Kiu, R.; Caim, S.; Painset, A.; Pickard, D.; Swift, C.; Dougan, G.; Mather, A.E.; Amar, C.; Hall, L.J. Phylogenomic analysis of gastroenteritis-associated Clostridium perfringens in England and Wales over a 7-year period indicates distribution of clonal toxigenic strains in multiple outbreaks and extensive involvement of enterotoxin-encoding (CPE) plasmids. Microb. Genom. 2019, 5, e000297. [Google Scholar] [CrossRef]
- Abdelrahim, A.M.; Radomski, N.; Delannoy, S.; Djellal, S.; Le Négrate, M.; Hadjab, K.; Fach, P.; Hennekinne, J.-A.; Mistou, M.-Y.; Firmesse, O. Large-Scale Genomic Analyses and Toxinotyping of Clostridium perfringens Implicated in Foodborne Outbreaks in France. Front. Microbiol. 2019, 10, 777. [Google Scholar] [CrossRef]
- Marmion, M.; Ferone, M.; Whyte, P.; Scannell, A. The changing microbiome of poultry meat; from farm to fridge. Food Microbiol. 2021, 99, 103823. [Google Scholar] [CrossRef]
- Lahti, P.; Lindström, M.; Somervuo, P.; Heikinheimo, A.; Korkeala, H. Comparative Genomic Hybridization Analysis Shows Different Epidemiology of Chromosomal and Plasmid-Borne cpe-Carrying Clostridium perfringens Type A. PLoS ONE 2012, 7, e46162. [Google Scholar] [CrossRef] [PubMed]
- Kaneko, I.; Miyamoto, K.; Mimura, K.; Yumine, N.; Utsunomiya, H.; Akimoto, S.; McClane, B.A. Detection of Enterotoxigenic Clostridium perfringens in Meat Samples by Using Molecular Methods. Appl. Environ. Microbiol. 2011, 77, 7526–7532. [Google Scholar] [CrossRef] [PubMed][Green Version]
- Heikinheimo, A.; Lindstrom, M.; Korkeala, H. Enumeration and Isolation of cpe-Positive Clostridium perfringens Spores from Feces. J. Clin. Microbiol. 2004, 42, 3992–3997. [Google Scholar] [CrossRef]
- Heikinheimo, A.; Lindström, M.; Granum, P.E.; Korkeala, H. Humans as reservoir for enterotoxin gene-carrying Clostridium perfringens type A. Emerg. Infect. Dis. 2006, 12, 1724–1729. [Google Scholar] [CrossRef] [PubMed]
- Eisel, D.; Seth, O.; Grünewald-Janho, S.; Kruchen, B.; Rüger, B. DIG Application Manual for Filter Hybridization; Editorial Roche Diagnostics GmbH: Mannheim, Germany, 2008. [Google Scholar]
- Public Health Agency of Canada. Estimates of the Number of Foodborne Illness Cases in Canada Ottawa. 2014. Available online: http://www.phac-aspc.gc.ca/efwdemoha/efbi-emoa-eng.php (accessed on 5 July 2016).
- Butler, A.J.; Pintar, K.D.; Thomas, M.K. Estimating the Relative Role of Various Subcategories of Food, Water, and Animal Contact Transmission of 28 Enteric Diseases in Canada. Foodborne Pathog. Dis. 2016, 13, 57–64. [Google Scholar] [CrossRef] [PubMed]
- Hill, W.E.; Payne, W.L.; Crouch, R.J.; Davis, V.M.; English, L.L.; Ferreira, J.L.; Gemski, P.; Jagow, J.A.; Moseley, S.L.; Noah, C.W.; et al. Genetic Methods for the Detection of Microbial Pathogens. Identification of Enterotoxigenic Escherichia coli by DNA Colony Hybridization: Collaborative Study. J. AOAC Int. 1984, 67, 801–807. [Google Scholar] [CrossRef]
- Grunstein, M.; Hogness, D.S. Colony hybridization: A method for the isolation of cloned DNAs that contain a specific gene. Proc. Natl. Acad. Sci. USA 1975, 72, 3961–3965. [Google Scholar] [CrossRef]
- Datta, A.R.; Wentz, B.A.; Hill, W.E. Detection of hemolytic Listeria monocytogenes by using DNA colony hybridization. Appl. Environ. Microbiol. 1987, 53, 2256–2259. [Google Scholar] [CrossRef]
- Todd, E.C.D.; Szabo, R.A.; MacKenzie, J.M.; Martin, A.; Rahn, K.; Gyles, C.; Gao, A.; Alves, D.; Yee, A.J. Application of a DNA Hybridization–Hydrophobic-Grid Membrane Filter Method for Detection and Isolation of Verotoxigenic Escherichia coli. Appl. Environ. Microbiol. 1999, 65, 4775–4780. [Google Scholar] [CrossRef]
- Ng, L.K.; Kingombe, C.I.; Yan, W.; Taylor, D.E.; Hiratsuka, K.; Malik, N.; Garcia, M.M. Specific detection and confirmation of Campylobacter jejuni by DNA hybridization and PCR. Appl. Environ. Microbiol. 1997, 63, 4558–4563. [Google Scholar] [CrossRef]
- Chandrashekhar, K.M.; Isloor, S.; Veeresh, B.H.; Hegde, R.; Rathnamma, D.; Murag, S.; Veeregowda, B.M.; Upendra, H.A.; Hegde, N.R. Limit of detection of genomic DNA by conventional PCR for estimating the load of Staphylococcus aureus and Escherichia coli associated with bovine mastitis. Folia Microbiol. 2015, 60, 465–472. [Google Scholar] [CrossRef] [PubMed]

| Hybridization Step | Buffers | Time/Temperature |
|---|---|---|
| Bacterial lysis and DNA denaturation | Denaturing solution: 0.5 M NaOH, 1.5 M NaCl | 5 min/Room T. |
| Neutralizing solution: 1.0 M Tris-HCl, 1.5 M NaCl, pH 7.4 | 5 min/Room T. | |
| 2 × saline sodium citrate (SSC): 0.3 M NaCl, 30 mM sodium citrate | 10 min/Room T. | |
| Pre-hybridization | Easy Buffer hyb | 1 h/42 °C |
| Hybridization of the probe | Easy Buffer hyb and probe | 2 h/42 °C |
| Membrane washing | Stringency buffer: 2 × SSC, 0.1% SDS | 2 × 5 min/Room T. |
| Stringency buffer: 0.5 × SSC, 0.1% SDS | 2 × 15 min (68 °C) | |
| Washing buffer B1 (kit DIG washing and blocking buffer set) | 5 min/Room T. | |
| Membrane blockage | Blocking buffer: B2 and B3 (kit DIG washing and blocking buffer set) | 30 min/Room T. |
| Antibody binding | Anti-DIG antibody and blocking buffer B2 and B3 (kit DIG washing and blocking buffer set) | 30 min/Room T. |
| Membrane washing | Washing buffer B1 (kit DIG washing and blocking buffer set) | 15 min/Room T. |
| Signal detection | Detection buffer B4: kit DIG washing and blocking buffer set | 5 min/Room T. |
| Detection buffer B4 + chromogenic solution (NBT/BCIP) | 14 h/Room T. in the dark | |
| Interruption of the chromogenic reaction | TE buffer (Tris-EDTA) | 5 min/Room T. |
| Sample Tube Identification | Bacterial Counts (cfu/mL) | ||
|---|---|---|---|
| Generic C. perfringens | Enterotoxigenic C. perfringens AHL 311 Control Strain | ||
| HGMF-CH approach | Tube 1 | 4.3 × 107 | 8.5 × 102 |
| Tube 2 | 1.3 × 106 | 5.8 × 103 | |
| Tube 3 | 6.5 × 107 | 1.71 × 103 | |
| Tube 4 | Sterile freezing medium | 2.5 × 103 | |
| DP-CH approach | Tube 5 | 4.3 × 107 | 8.5 × 102 |
| Tube 6 | 1.76 × 105 | 1.43 × 103 | |
| Tube 7 | 5.6 × 107 | 8.5 × 105 | |
| Probes Synthesized in the Current Study | Probe Concentration (ng/µL) |
|---|---|
| Assay 1 | 4.57 |
| Assay 2 | 25.8 |
| Assay 3 | 35.2 |
| Assay 4 | 46.2 |
| Assay 5 | 37.6 |
| Assay 6 | 51.9 |
| Assay 7 | 54.8 |
Disclaimer/Publisher’s Note: The statements, opinions and data contained in all publications are solely those of the individual author(s) and contributor(s) and not of MDPI and/or the editor(s). MDPI and/or the editor(s) disclaim responsibility for any injury to people or property resulting from any ideas, methods, instructions or products referred to in the content. |
© 2023 by the authors. Licensee MDPI, Basel, Switzerland. This article is an open access article distributed under the terms and conditions of the Creative Commons Attribution (CC BY) license (https://creativecommons.org/licenses/by/4.0/).
Share and Cite
Kakese Mukosa, R.; Thibodeau, A.; Morris Fairbrother, J.; Thériault, W.; Gaucher, M.-L. Addressing Current Challenges in Poultry Meat Safety: Development of a Cultivation and Colony Hybridization Approach to Recover Enterotoxigenic Clostridium perfringens from Broiler Chicken Carcasses. Pathogens 2024, 13, 30. https://doi.org/10.3390/pathogens13010030
Kakese Mukosa R, Thibodeau A, Morris Fairbrother J, Thériault W, Gaucher M-L. Addressing Current Challenges in Poultry Meat Safety: Development of a Cultivation and Colony Hybridization Approach to Recover Enterotoxigenic Clostridium perfringens from Broiler Chicken Carcasses. Pathogens. 2024; 13(1):30. https://doi.org/10.3390/pathogens13010030
Chicago/Turabian StyleKakese Mukosa, Rosette, Alexandre Thibodeau, John Morris Fairbrother, William Thériault, and Marie-Lou Gaucher. 2024. "Addressing Current Challenges in Poultry Meat Safety: Development of a Cultivation and Colony Hybridization Approach to Recover Enterotoxigenic Clostridium perfringens from Broiler Chicken Carcasses" Pathogens 13, no. 1: 30. https://doi.org/10.3390/pathogens13010030
APA StyleKakese Mukosa, R., Thibodeau, A., Morris Fairbrother, J., Thériault, W., & Gaucher, M.-L. (2024). Addressing Current Challenges in Poultry Meat Safety: Development of a Cultivation and Colony Hybridization Approach to Recover Enterotoxigenic Clostridium perfringens from Broiler Chicken Carcasses. Pathogens, 13(1), 30. https://doi.org/10.3390/pathogens13010030

